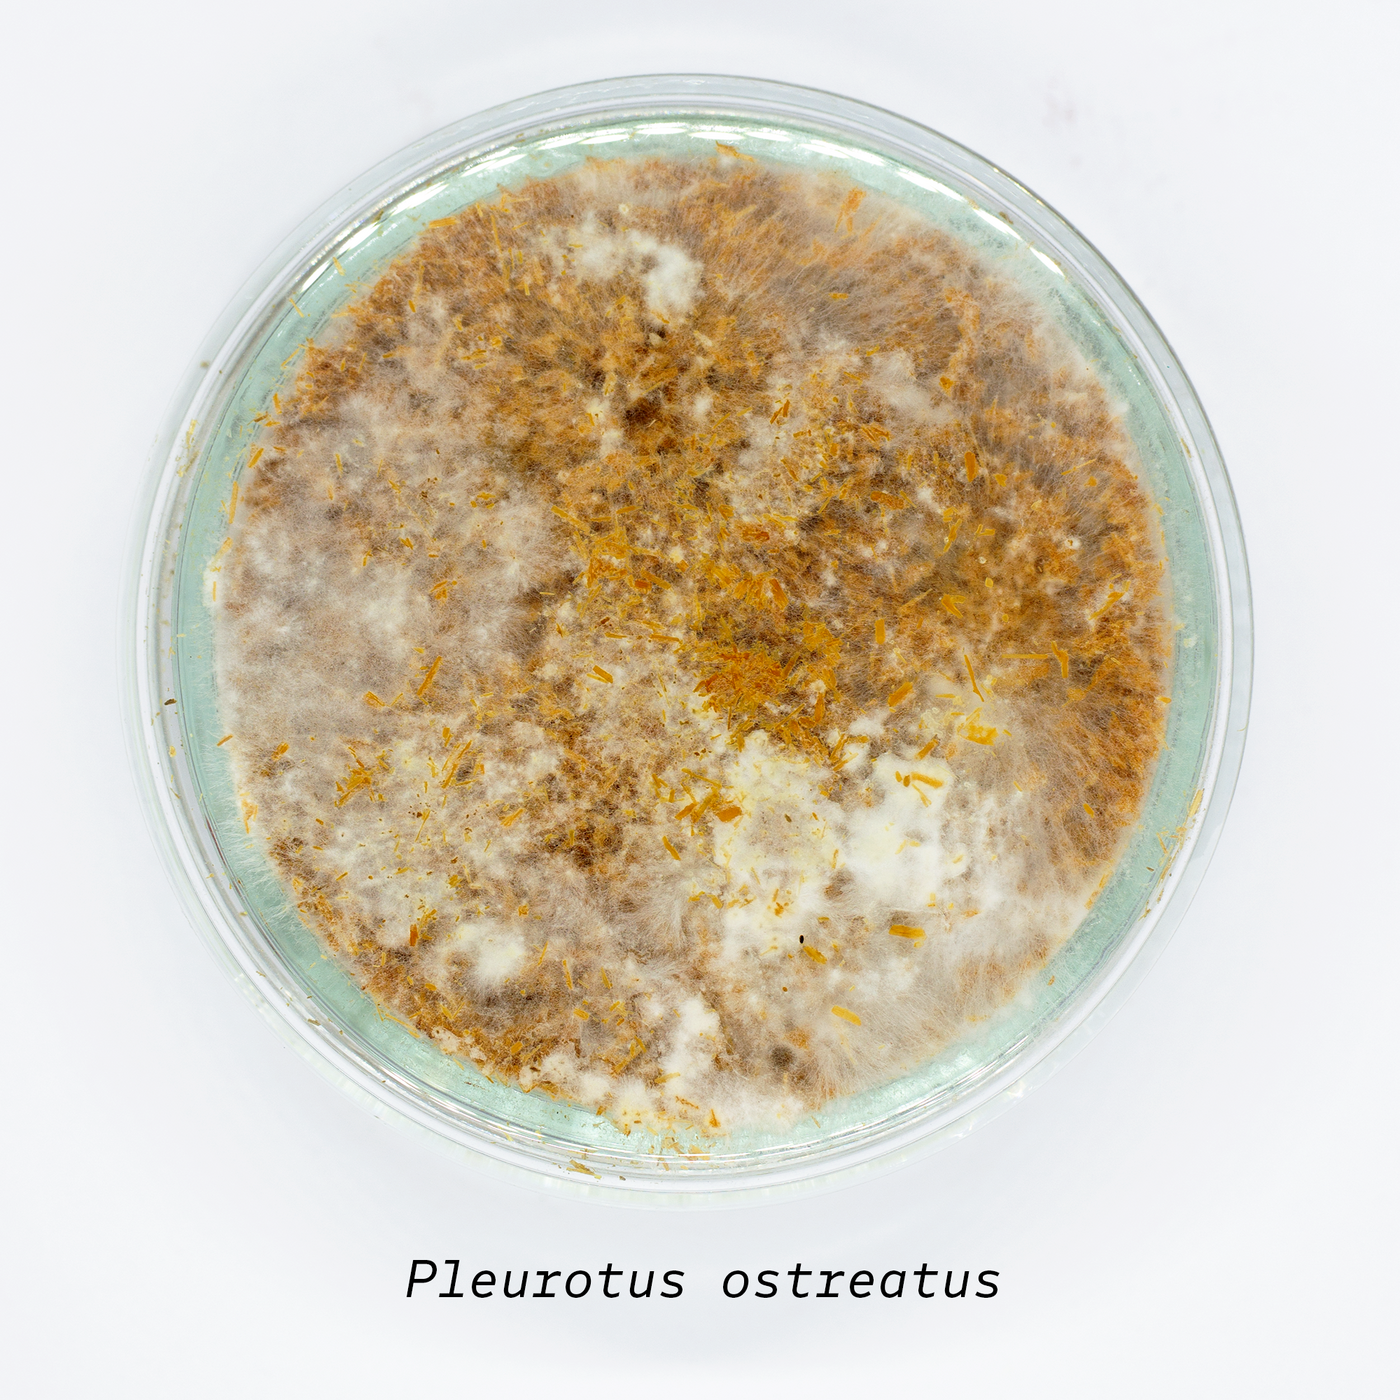
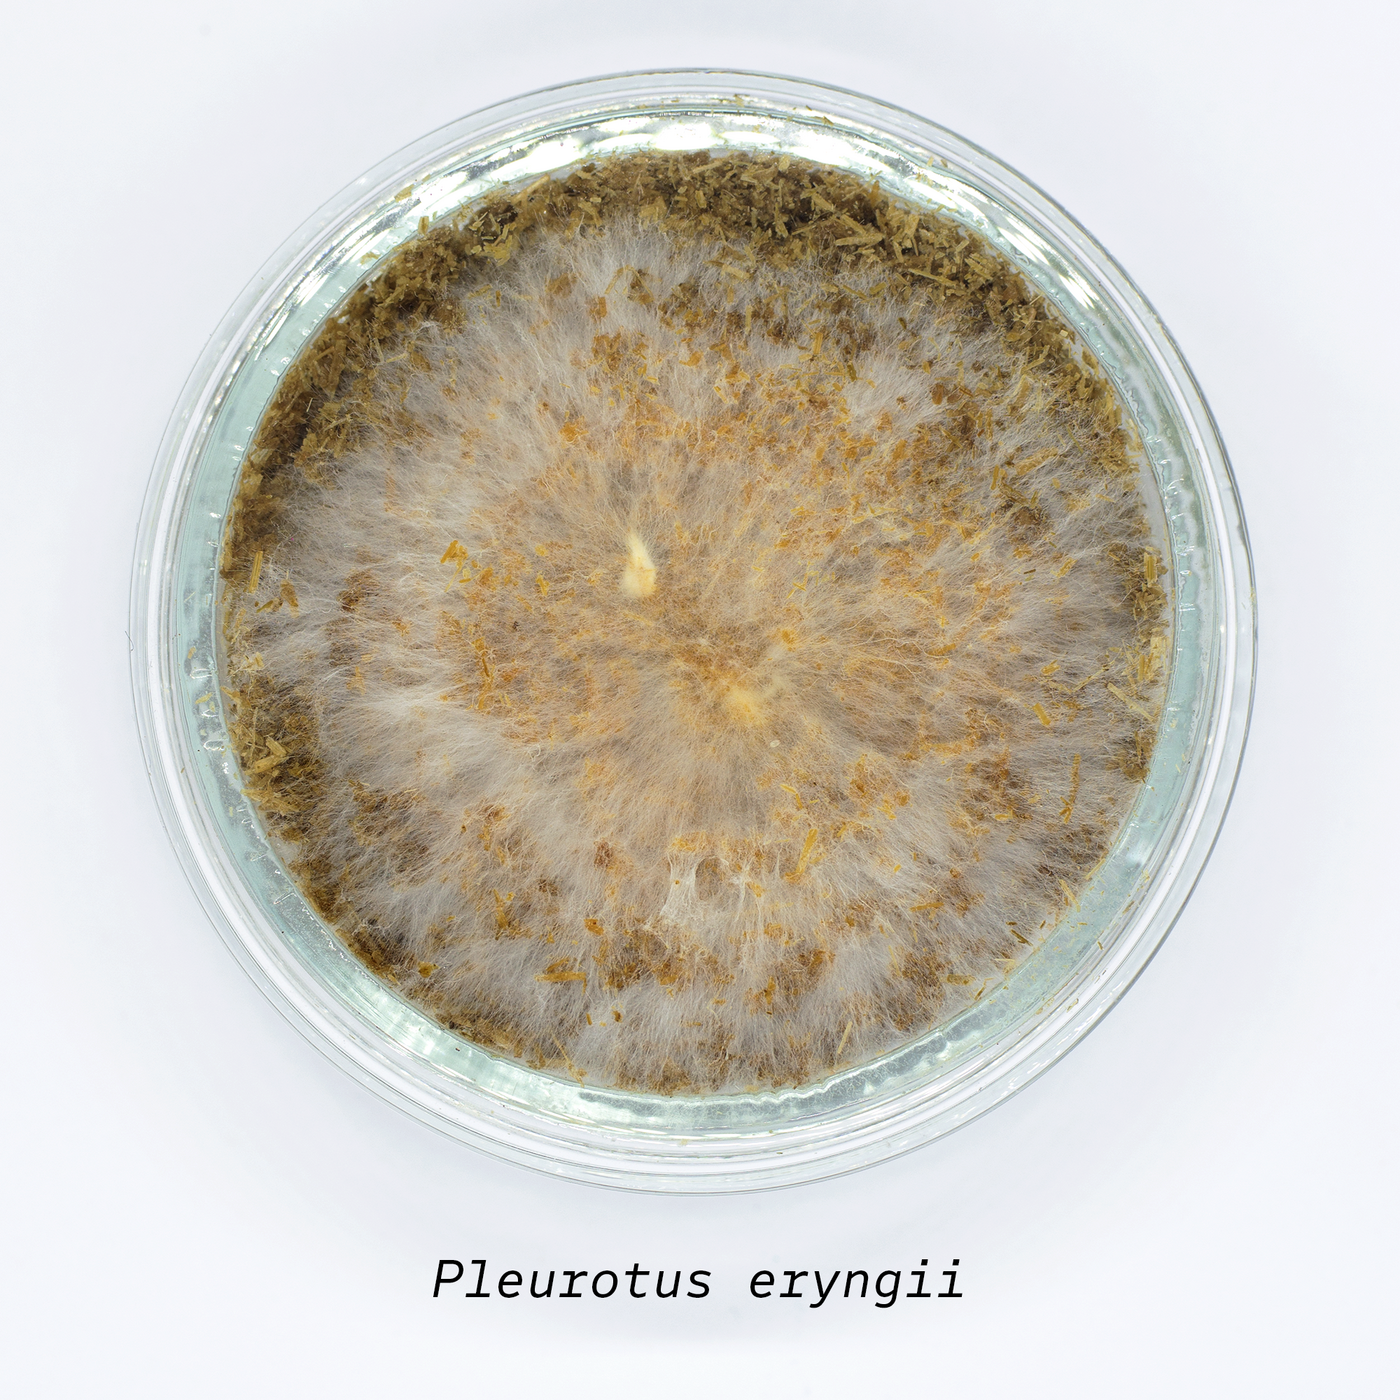
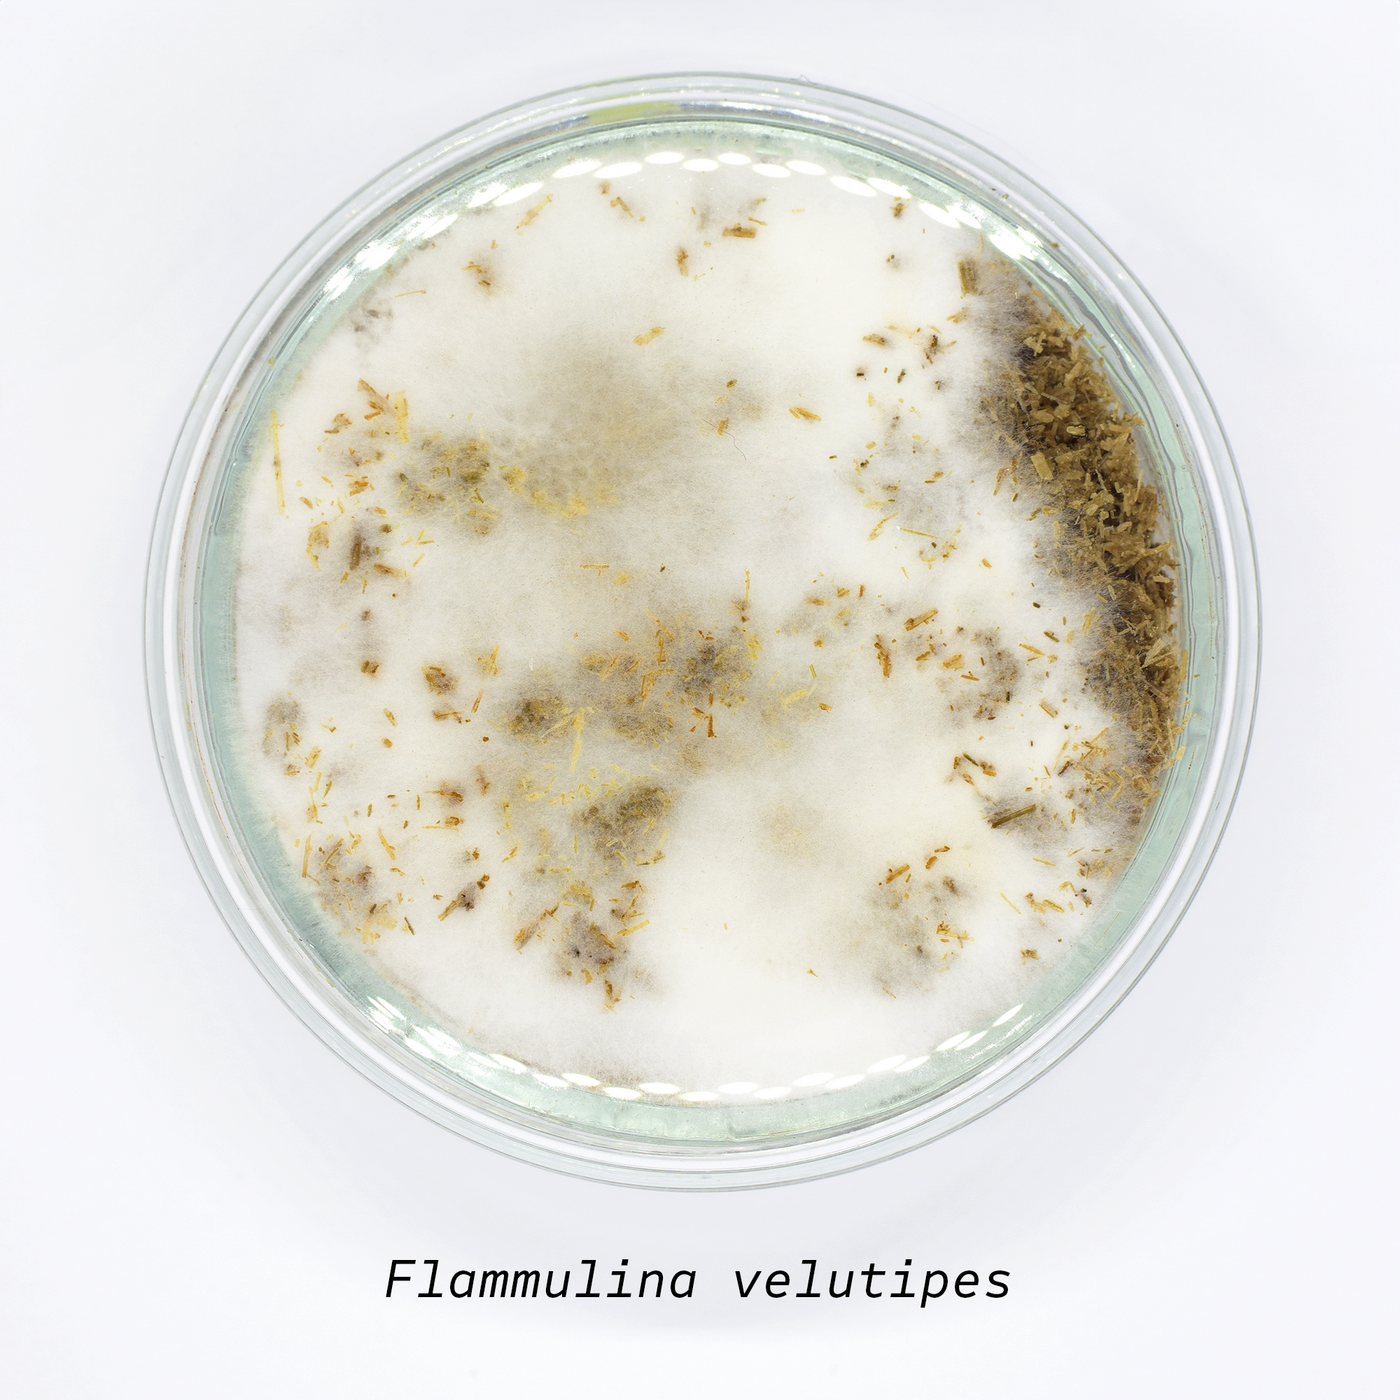
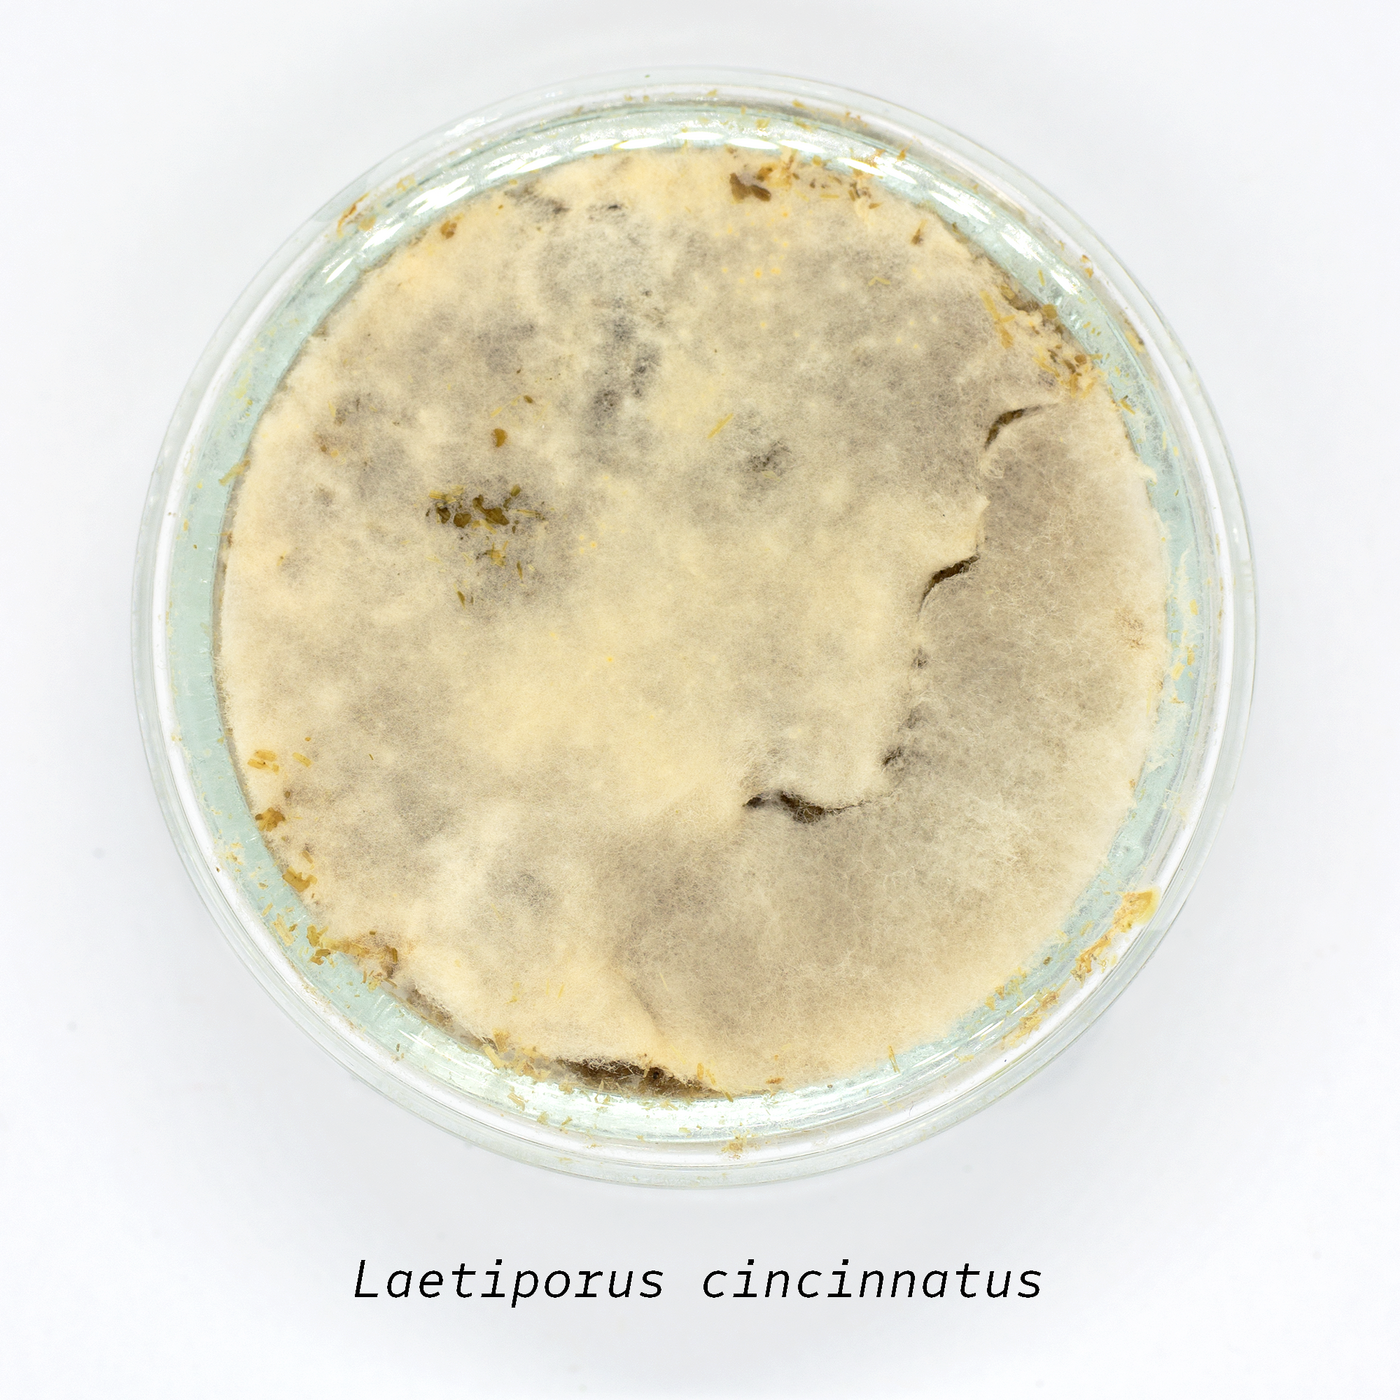
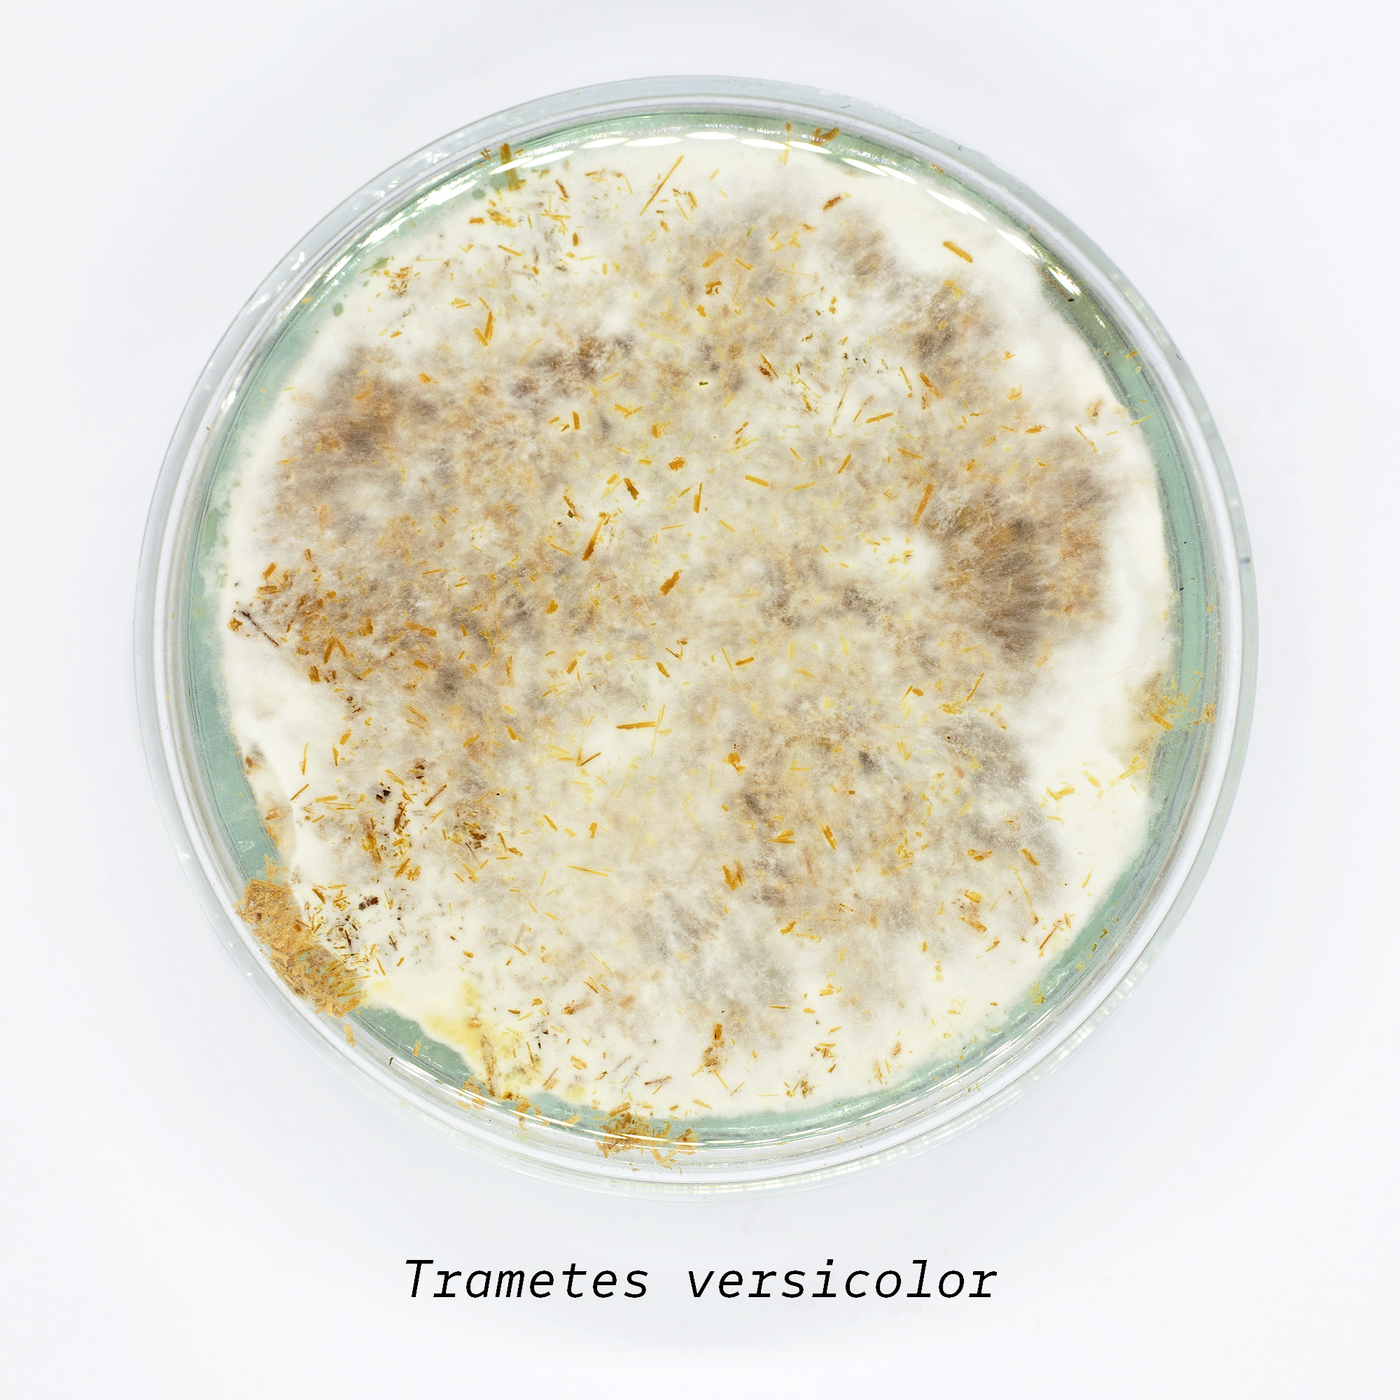

Das Konzept des dreidimensional gewachsenen Schuhs, die im Projekt Habitat entstand, fand in Re/boot ihre prototypische Umsetzung. Dabei konzentrierten wir uns bewusst auf den Einsatz von Pilzen. Ihre Vielfalt an Materialeigenschaften – besonders die Kombination von Myzel und Fruchtkörpern – hatte ausreichend Potenzial, die unterschiedlichen Anforderungen eines Schuhs abzudecken. Gleichzeitig half die Fokussierung auf eine Organismenart, die Komplexität zu reduzieren, denn die gleichzeitige Kultivierung verschiedener Organismen stellt für sich bereits eine große Herausforderung dar.
Vom Pilz zum funktionalen Schuh
Für die verschiedenen Funktionsbereiche des Schuhs wählten wir unterschiedliche Pilzarten sowie verschiedene Bestandteile der komplexen Organismen aus. Für den Schaft und den flexiblen Teil der Sohle bot sich der Einsatz von Myzel an, da es nicht nur schnell wächst, sondern auch selbstheilende und bindende Eigenschaften besitzt. So kann sich der Schuhschaft bei kleinen Beschädigungen teilweise selbst reparieren.
Wir begannen damit, auf eine dünne Schicht nährstoffangereicherten Hydrogels Stücke von Pilzmyzel aufzubringen. Das Myzel wuchs innerhalb kurzer Zeit über die gesamte Oberfläche des Schuhschafts und bildete so eine durchgehende, lebendige Materialschicht.